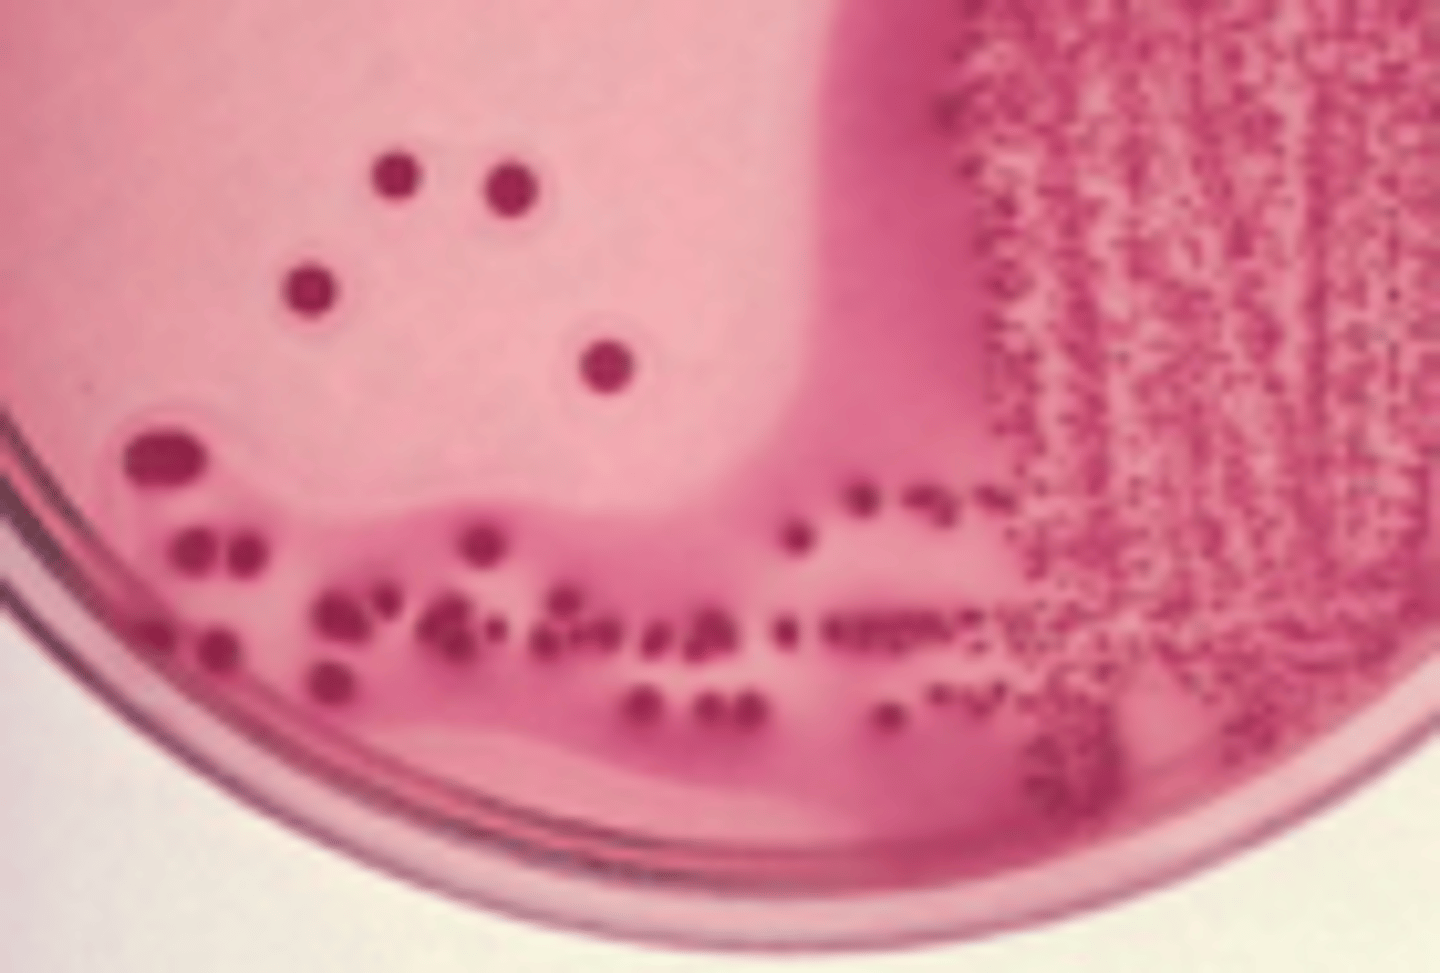
<p>dry, pink colonies; may be LF or NLF, produce a haze in the agar</p>
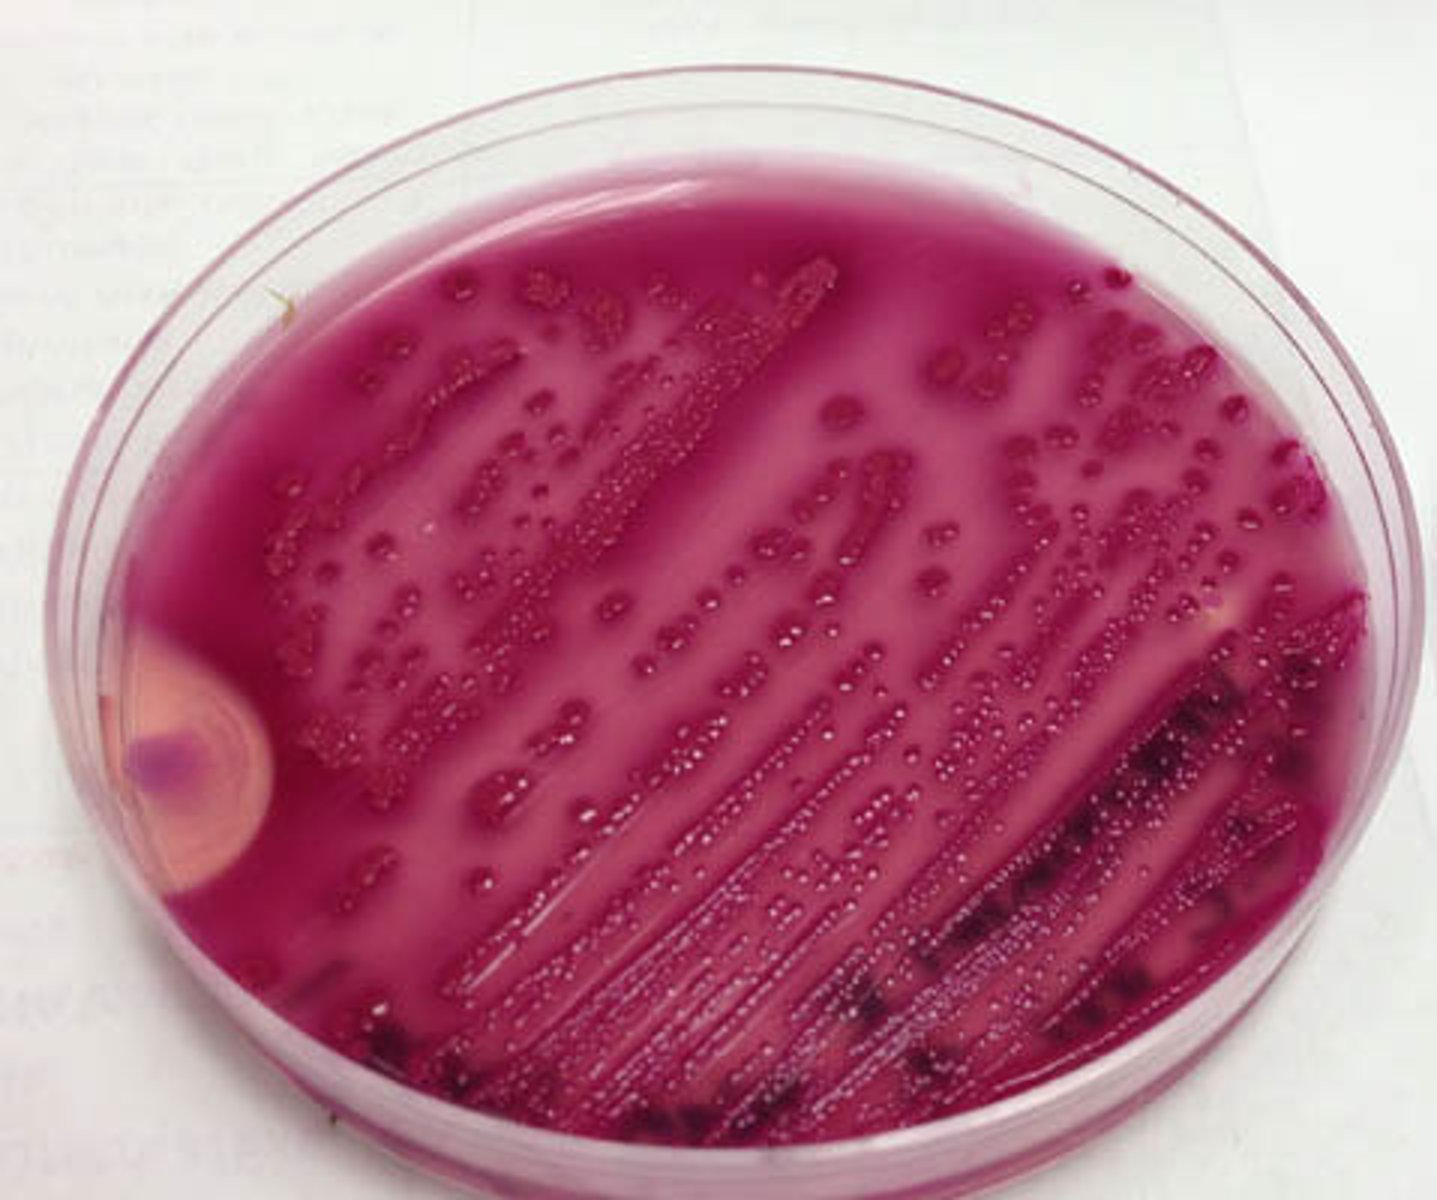
<p>LF (pink)</p><p>Indole negative </p>
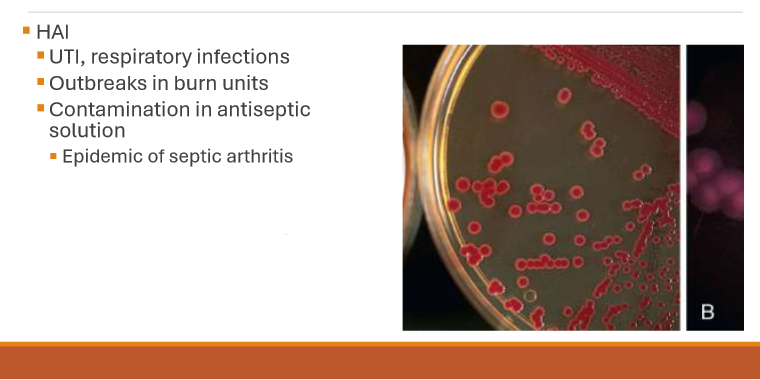
<p>Serratia marcescens</p>
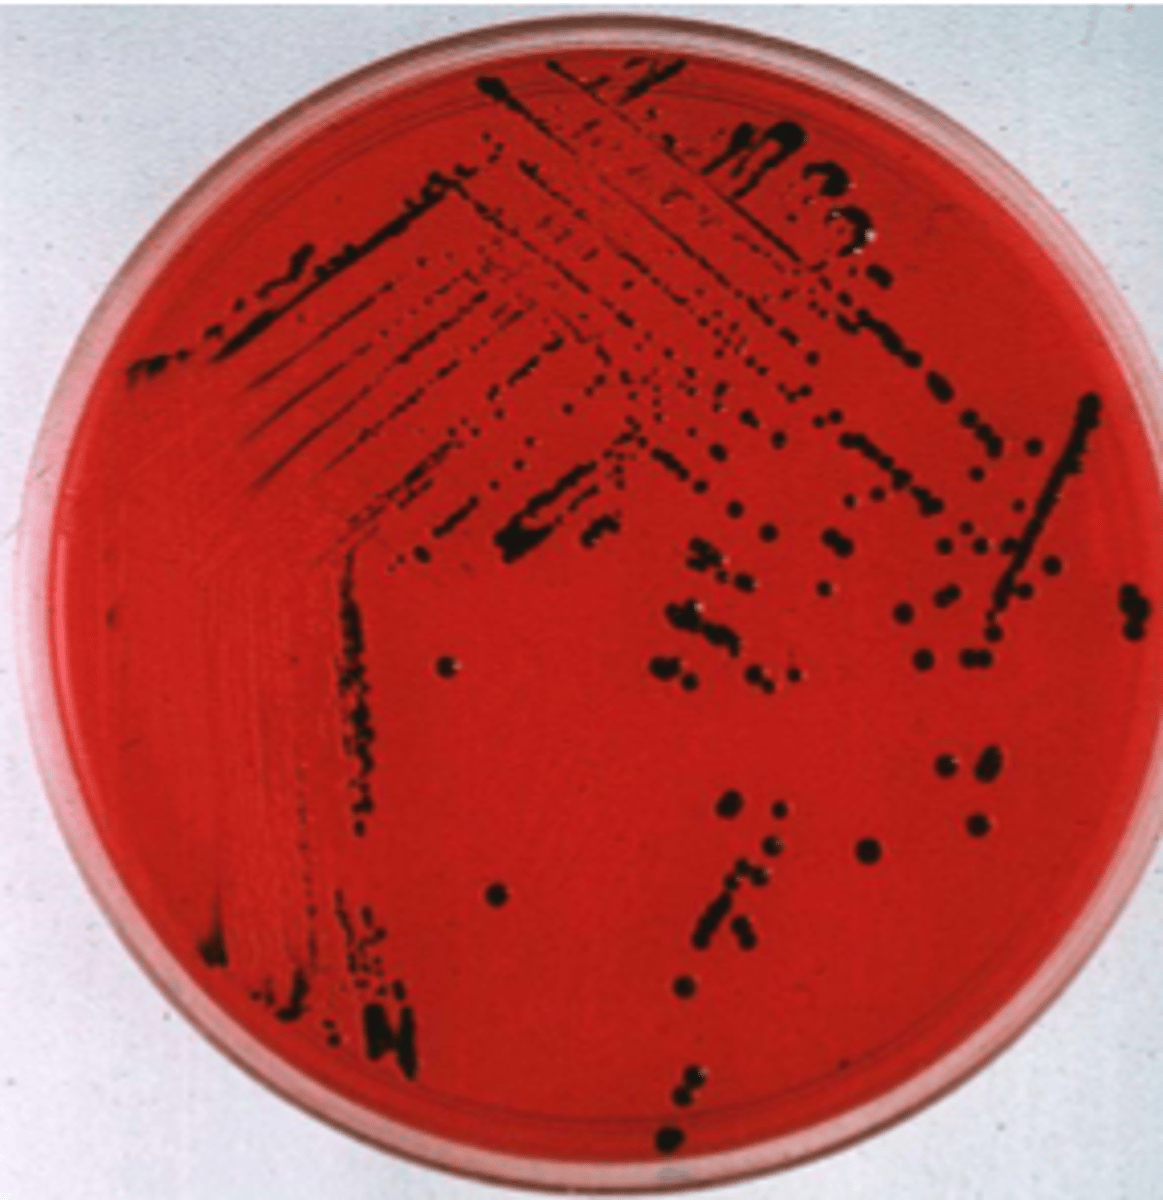
<p>clear, NLF (MAC) and black center (HE and XLD)</p>
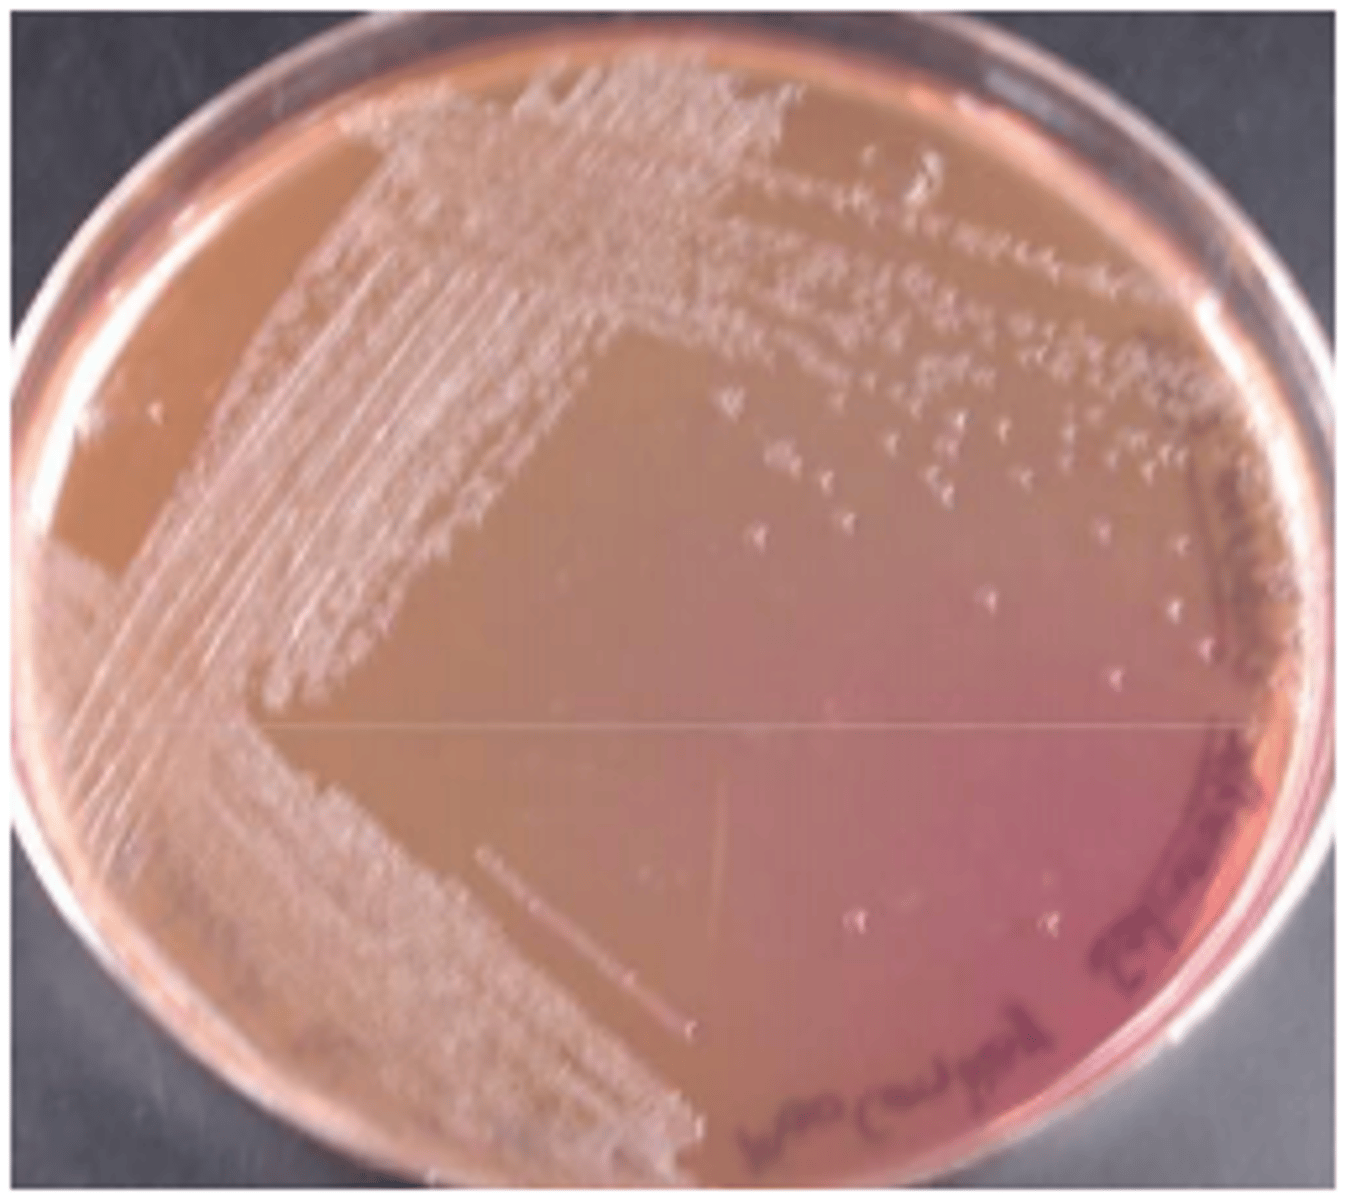
<p>clear/NLF</p>
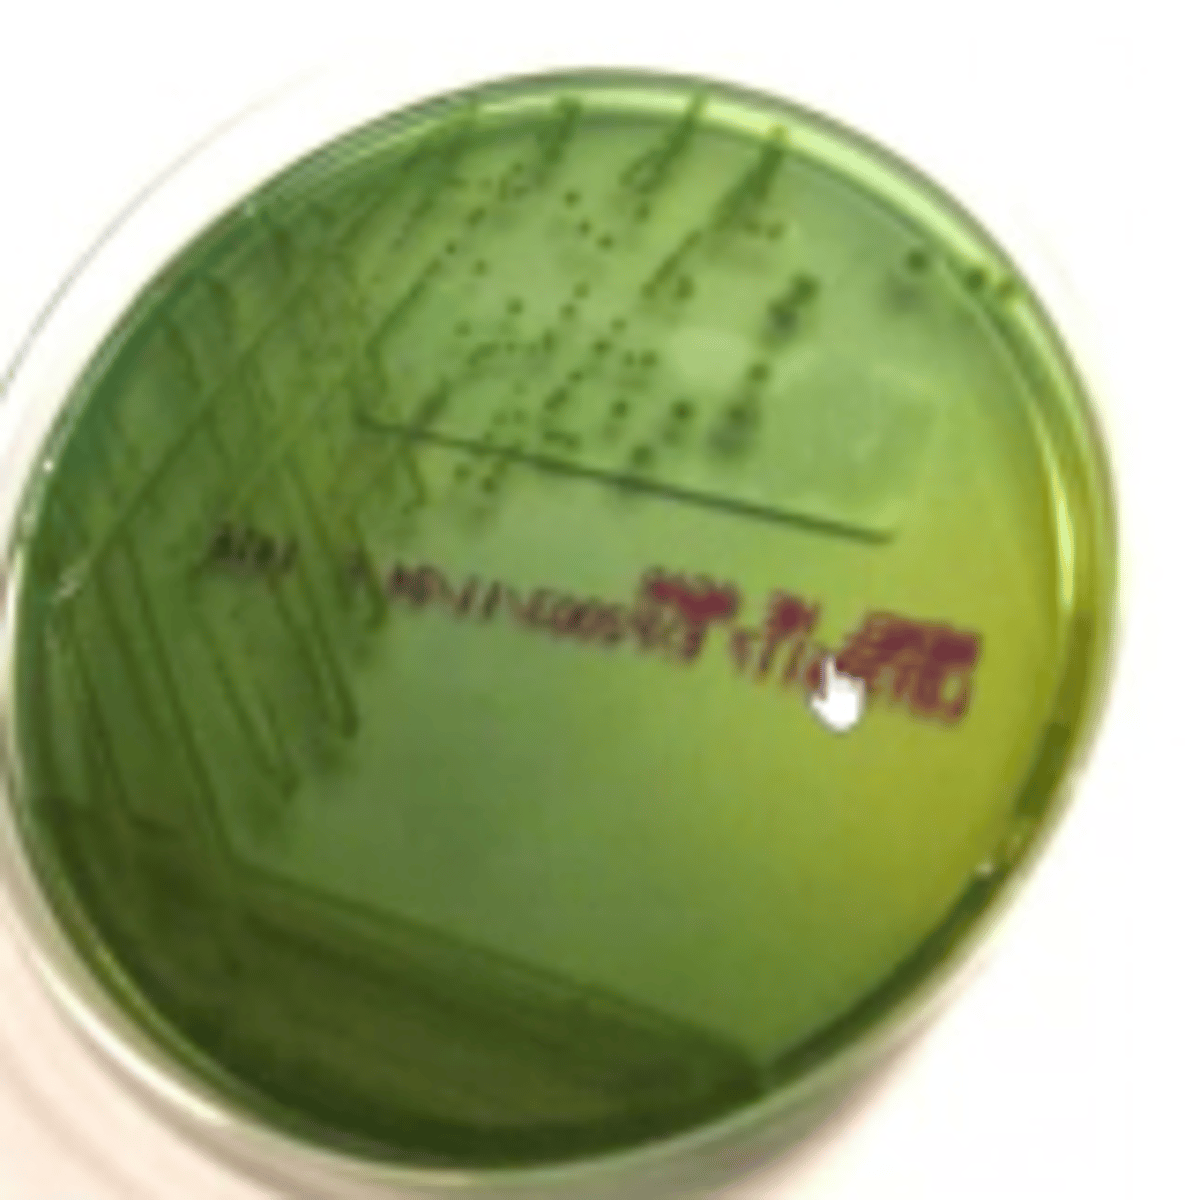
<p>blue/green color with black point</p>
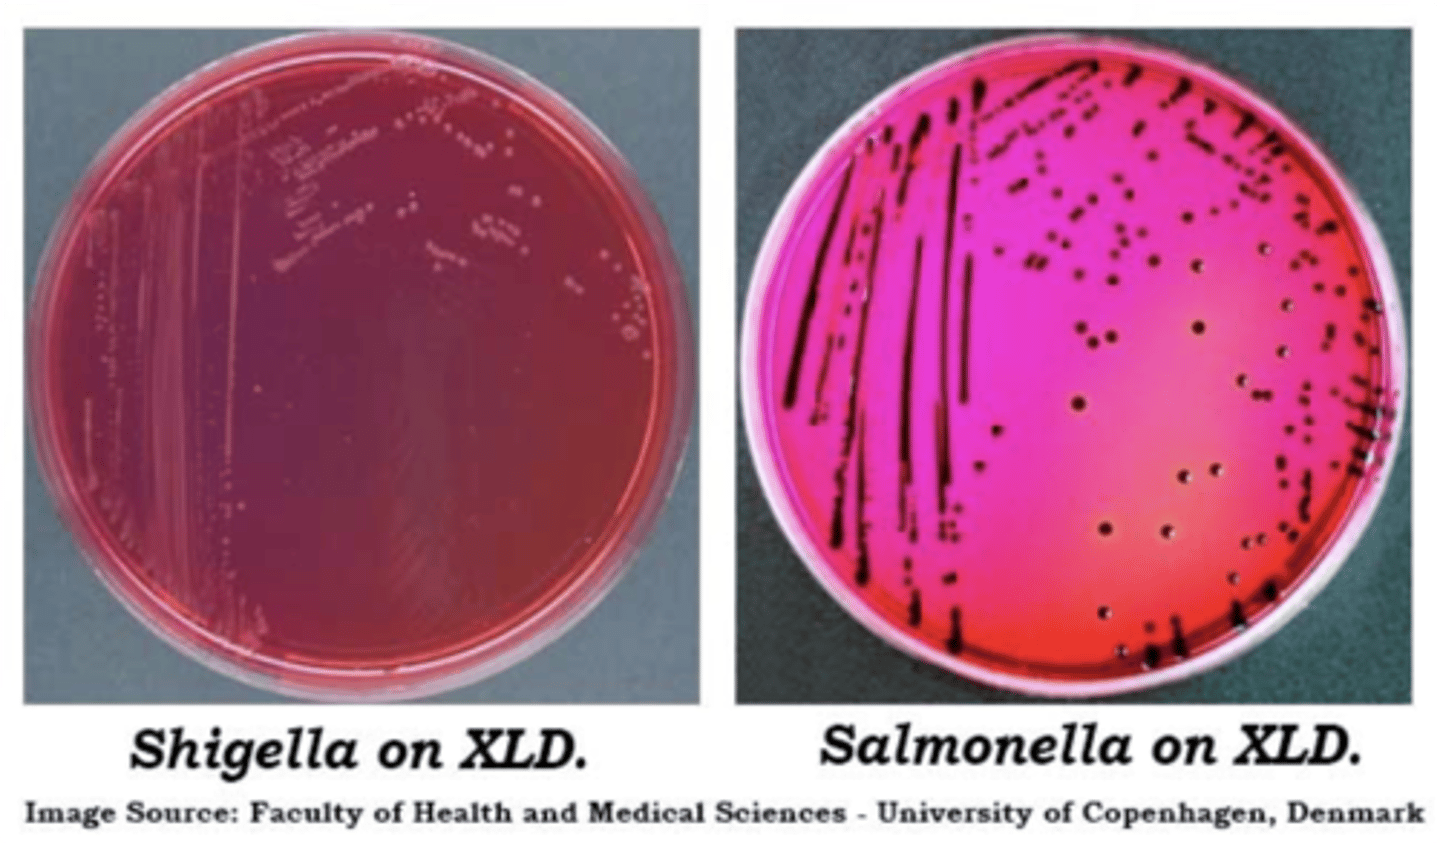
<p>colorless/red from agar</p>
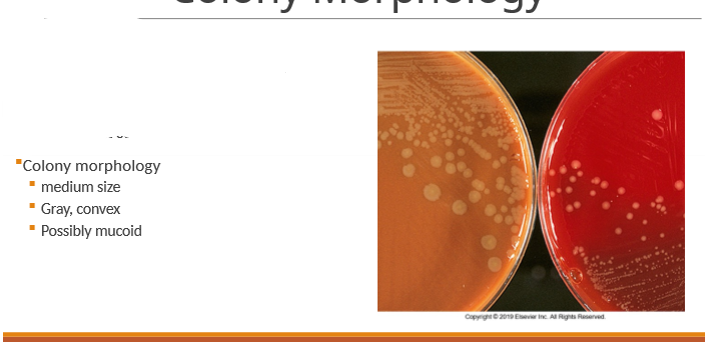
<p>only positive for glucose </p>

1/94
Enterobacterales -Mis. GNR Sp 26 Stud ... - Miscellaneous Organi ...
Name | Mastery | Learn | Test | Matching | Spaced | Call with Kai |
|---|
No analytics yet
Send a link to your students to track their progress
Enterobacteriaceae is not a what ?
Genus is a group of organisms, not a genus or species
What is the gram stain of members in Enterobacteriaceae?
gram negative bacilli or coccobacilli
What media will Enterobacteriaceae grow on?
BAP, CHOC, and MAC
What is the common name used for Enterobacteriaceae?
enterics
Also ferment glucose
What is the expected oxidase result for almost all members of Enterobacteriaceae?
negative
Except for Plesiomonas
What organisms of the Enterobacteriaceae class do not show motility at body temperature?
klebsiella
shigella
yersinia
What are Enterobacteriaceae environmental conditions?
facultative anaerobes (grow with or without oxygen)
How do Enterobacteriaceae colonies appear on BAP?
large and grey (possible mucoid and beta hemolysis)
What do pathogens look like on a SMAC plate?
colorless possible E. coli O157:H7
What does normal flora look like on a SMAC plate?
pink/red
What do pathogens look like on a HE plate?
blue/green color with a black point - with or without black point - pathogens Salmonella and Shigella
What does normal flora look like on an HE(Hektoen enteric) plate?
orange color
What do pathogens look like on an XLD plate?
clear/red = shigella
red with black centers = salmonella
What does normal flora look like on an XLD plate?
yellow color or with black centers
What organism is the SMAC plate screening for?
E. coli O157:H7
What is E. coli O157:H7 colony morphology?
colorless on SMAC
What is an extended spectrum beta lactamase (ESBL)?
can be produced by gram-negative bacteria, rending cephalsoporins and other beta-lactam antibiotics inactive. These genes can be transmitted between organsims through plasmid conjugation (carries drug resistance gene)
antibiotic resistance through plasmids
Where are O antigens found?
cell wall (somatic)
Where are H antigens found?
flagellar antigen → motility
Where are K antigens found?
capsule antigen
Enterobacterales Clinical Significance
Most reside in GI tract → Except Salmonella, Shigella and Yersinia
Opportunistic pathogens
Normal flora
Cause infections in "not normal" sites
- Septicemia, wounds, UTI, meningitis
Primary Enterobacteriaceae Pathogens
salmonella
shigella
yersinia
What is the location in the human body of most members of Enterobacteriaceae?
GI tract
What organism is the #1 cause of urinary tract infections?
Escherichia coli (E. coli)
Enterotoxigenic (ETEC)
Traveler’s Diarrhea
Which type of E. coli infection can cause blood in the stool and lead to hemolytic uremic syndrome?
Enterohemorrhagic (EHEC) → E. coli O157:H7 makes Shiga toxin and identified by SMAC
Extraintestinal Infections From E. coli
Septicemia and meningitis
· 40% of all gram negative meningitis among neonates
. Newborn acquires infection in birth canal during/right before delivery
. Capsule antigen K1
- Virulence factor associated with neonatal meningitis
E. coli Colony Morphology
dry, pink colonies; may be LF or NLF, produce a haze in the agar
E. coli Tests
oxidase negative and indole positive - not swarming
Klebsiella pneumoniae Colony Morphology
LF, moist/mucoid


Klebsiella pneumoniae Tests
indole negative
Klebsiella pneumoniae Virulence
Polysaccharide Capsule and prevents phagocytosis and antimicrobials
What are the most common species of Enterobacter?
Enterobacter cloacae and Klebsiella aerogenes.
Enterobacter cloacae and Klebsiella aerogenes. Colony Morphology on MAC Plate
LF (pink)
Indole negative
Citrobacter Species
. 12 species
. Citrobacter freundii is most common
Nosocomial UTIs, pneumonias, endocarditis in drug users, intra-abdominal abscesses
. Identification characteristics
Weak urease
Lactose fermenter
What organism is highly resistant to antimicrobials and can produce a red pigment at room temperature?
Serratia marcescens
Proteus Colony Morphology
NLF, swarms on BAP, distinct bad smell
Proteus vulgaris Test ID
indole postive - does not swarm as much as Proteus mirabilis
Proteus mirabilis Test ID
indole negative
Salmonella
. Inhabit Gl tracts of animals
. Infection through contaminated or undercooked animal food products
Shigella
. Human carriers coupled with improper sanitary conditions and poor personal hygiene
Salmonella Colony Morphology
clear, NLF (MAC) and black center (HE and XLD)
Salmonella Tests
indole negative
urease positive
most produce H2S
Salmonella Virulence Factors
- Fimbriae required for adhesion to intestine
- Invasion factors (ability to transverse intestinal mucosa)
- Enterotoxin involved in gastroenteritis
Salmonella Antigenic Structures
O and H antigens
capsular antigen Vi
Salmonella Clinical Manifestations
-Acute gastroenteritis (food poisoning)
-septicemia/bacteremia
-enteric (typhoid fever)
Salmonella is caused by
organism not by toxins
Poultry,milk,eggs, pet handinling
Symptoms 8-36 hours
What organism is the major cause of Typhoid fever?
Salmonella enterica - typhi serotype
Shigella Colony Morphology on MAC
clear/NLF
Shigella Colony Morphology on HE
blue/green color with black point
Shigella Colony Morphology on XLD
colorless/red from agar
Shigella Clinical Manifestation
Low inoculum:10-200 organism
fever, chills, cramps, watery diarrhea, bloody mucus
Shigella
Nonmotile
Clear, NLF
Antigenic Structures
O and K antigens
Lack H antigen
Nonmotile (SKY acronym)
What are the 4 types of Shigella species and their groups?
S. dysenteriae (Group A)
S. flexneri (Group B)
S. boydii (Group C)
S. sonnet (Group D)

fermenters
ferment carbohydrates
Nonfermenters
do not ferment carbohydrates
Gram Stain of Nonfermenters
long, thin, gram neg bacilli
Environmental Requirements of Nonfermenters
aerobic, moist, heat
What nonfermenter organism genus is seen most often in the clinical laboratory?
Pseudomonas aeruginosa
What organism has a fruity odor, metallic sheen, and is a nonlactose fermenter?
Pseudomonas aeruginosa
If you have growth of an organism on a MAC plate- do you need to perform a gram stain? Why or why not?
yes - further ID gram neg ??
Pseudomonas aeruginosa Clinical Manifestations
-HAI pneumonia, resp tract infections, bacteremia
-skin rashes (hot tub syndrome)
-ear infections
-endocarditis
-wound infections and burn patients
-pulmonary infections (CF patients)
hot tub syndrome
Which organism can cause very serious lung complications in patients with cystic fibrosis?
Burkholderia cepacia
What is the oxidase result for most nonfermenters?
positive
Which 2 organisms highlighted in lecture have a negative oxidase result?
S. maltophilia
Enterobacteriaceae?
What is different about the gram stain in Acinetobacter spp.?
pleomorphic forms and coccoid
Acinetobacter Colony Morphology
purple hue on MAC but NLF (sacrolytic)

Acinetobacter Clinical Manifestations
UTI, pneumonia, endocarditis, septicemia, meningitis, wounds, burns, eye infections
S. Maltophilia Colony Morphology
"Blue hue on MAC agar
"Nonfermenting, gram negative rod
"Oxidase negative
"Catalase positive
S. Maltophilia Clinical Manifestations
resp infection, pneumonia, endocarditic, wound infections, bacteremia
What organism produces a weak, slow positive oxidase reaction nonfluorescent yellow or green pigment?
Burkholderia cepacia
What two nonfermentive gram negative rods have flagella?
Alcaligenes
Achromobacter
oxidase positive
What is the gram stain for Neisseria species and Moraxella catarrhalis?
gram negative diplococci (may be intra or extracellular)
Is a gram stain recommended for a pharyngeal swab of N. gonorrhoeae?
No
Using CTA, what carbohydrate does N. gonorrhoeae test positive for?
glucose
What contributes to the epidemiolgy of N. meningitidis?
crowded living conditions (military and college dorms)
N. meningitides Clinical Manifestations
Septecemia
Meningitis
Meningococcemia
Hemorrhage in adgrenal glands (Waterhouse-Friderchsen syndrome)
What is the colony morphology for N. meningitidis?
medium, grey, possibly mucoid
What CTA sugars is N. meningitidis positive for?
glucose and maltose
Does N. meningitidis need to be worked up under a hood?
Yes
Which organism tests positive using a butyrate esterase reaction?
M. catarrhalis
What is the gram stain for Haemophilus?
gram negative bacilli/coccobacilli
What are the growth factors for Haemophilus?
X and V
What is satellitisim?
the growth of fastidious organism around other bacteria that release the necessary growth factors
Will Haemophilus grow on either a BAP or MAC?
no - only has X factor
What are anaerobes?
Anaerobes are organisms that grow without air and require oxygen-free conditions to live.
What are exogenous anaerobes?
organisms that are outside the body
What are endogenous anaerobes?
organism inside the body that become source of infection
What are potential factors for anaerobic infections?
trauma
vascular stasis
reduced environment (wound)
What are common sites for anaerboes within the body?
Skin
Respiratory tract
GI tract
Genitourinary tract
What are obligate anaerobes?
organisms that cannot survive in the presence of oxygen
Where would growth be seen in broth if anaerobes are present?
the bottom of the tube
Neisseria spp. General Characteristics
"Gram stain: gram negative diplococci intracellular and extracellular
" Kidney bean or baby butt
Aerobic
"Nonmotile
Nonspore forming
Catalase positive
"Oxidase positive
asymptomatic infection is uncommon in men
and 50 % of owmen can be asymptomatic
N. gonorrhoeae
only positive for glucose
N. meningitides infection
postive for both glucose and maltose and if any specimens needed to worked up under a hood if suppites for this